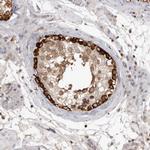
c-Cbl Antibody in Immunohistochemistry (Paraffin) (IHC (P))

Search
Invitrogen
c-Cbl Polyclonal Antibody
{{$productOrderCtrl.translations['antibody.pdp.commerceCard.promotion.promotions']}}
{{$productOrderCtrl.translations['antibody.pdp.commerceCard.promotion.viewpromo']}}
{{$productOrderCtrl.translations['antibody.pdp.commerceCard.promotion.promocode']}}: {{promo.promoCode}} {{promo.promoTitle}} {{promo.promoDescription}}. {{$productOrderCtrl.translations['antibody.pdp.commerceCard.promotion.learnmore']}}

Please note: We are reviewing Western blot images included in the antibody testing data in our catalog, including those provided by third parties. Unless expressly labeled or annotated as “raw-unedited”, Western blot images included in the antibody testing data in our catalog may have been edited, optimized or otherwise adjusted for presentation.
产品信息
PA5-82992
种属反应
已发表种属
宿主/亚型
分类
类型
抗原
偶联物
形式
浓度
规格
纯化类型
保存液
内含物
保存条件
运输条件
RRID
产品详细信息
Immunogen sequence: PTTNVTEGSQ VPERPPKPFP RRINSERKAG SCQQGSGPAA SAATASPQLS SEIENLMSQG YSYQDIQKAL VIAQNNIEMA KNILREFVSI SSPAHVA
Highest antigen sequence indentity to the following orthologs: Mouse - 83%, Rat - 84%.
靶标信息
Cbl proteins are a family of ubiquitin protein ligases (E3s) that negatively regulate signaling by targeting activated tyrosine kinases for degradation. Cbl- c is the most recently cloned member of the Cbl proteins and is expressed only in epithelial cells (the other Cbl proteins are ubiquitously expressed). Cbl-c, like the other mammalian Cbl proteins, can ubiquitinate the activated EGFR and target it for degradation. Through interactions with proteins containing SRC homology-2 (SH2) and SH3 domains, CBL proteins modulate downstream cell signaling.
仅用于科研。不用于诊断过程。未经明确授权不得转售。
生物信息学
蛋白别名: Cas-Br-M (murine) ecotropic retroviral transforming sequence; Casitas B-lineage lymphoma; Casitas B-lineage lymphoma proto-oncogene; Cbl proto-oncogene, E3 ubiquitin protein ligase; CBL-3; CBLC; E3 ubiquitin-protein ligase CBL; Proto-oncogene c-Cbl; RING finger protein 55; RING-type E3 ubiquitin transferase CBL; RNF57; Signal transduction protein CBL
基因别名: 4732447J05Rik; c-Cbl; CBL; Cbl-2; CBL2; RGD1561386; RNF55
UniProt ID: (Mouse) P22682
Entrez Gene ID: (Mouse) 12402, (Rat) 500985




